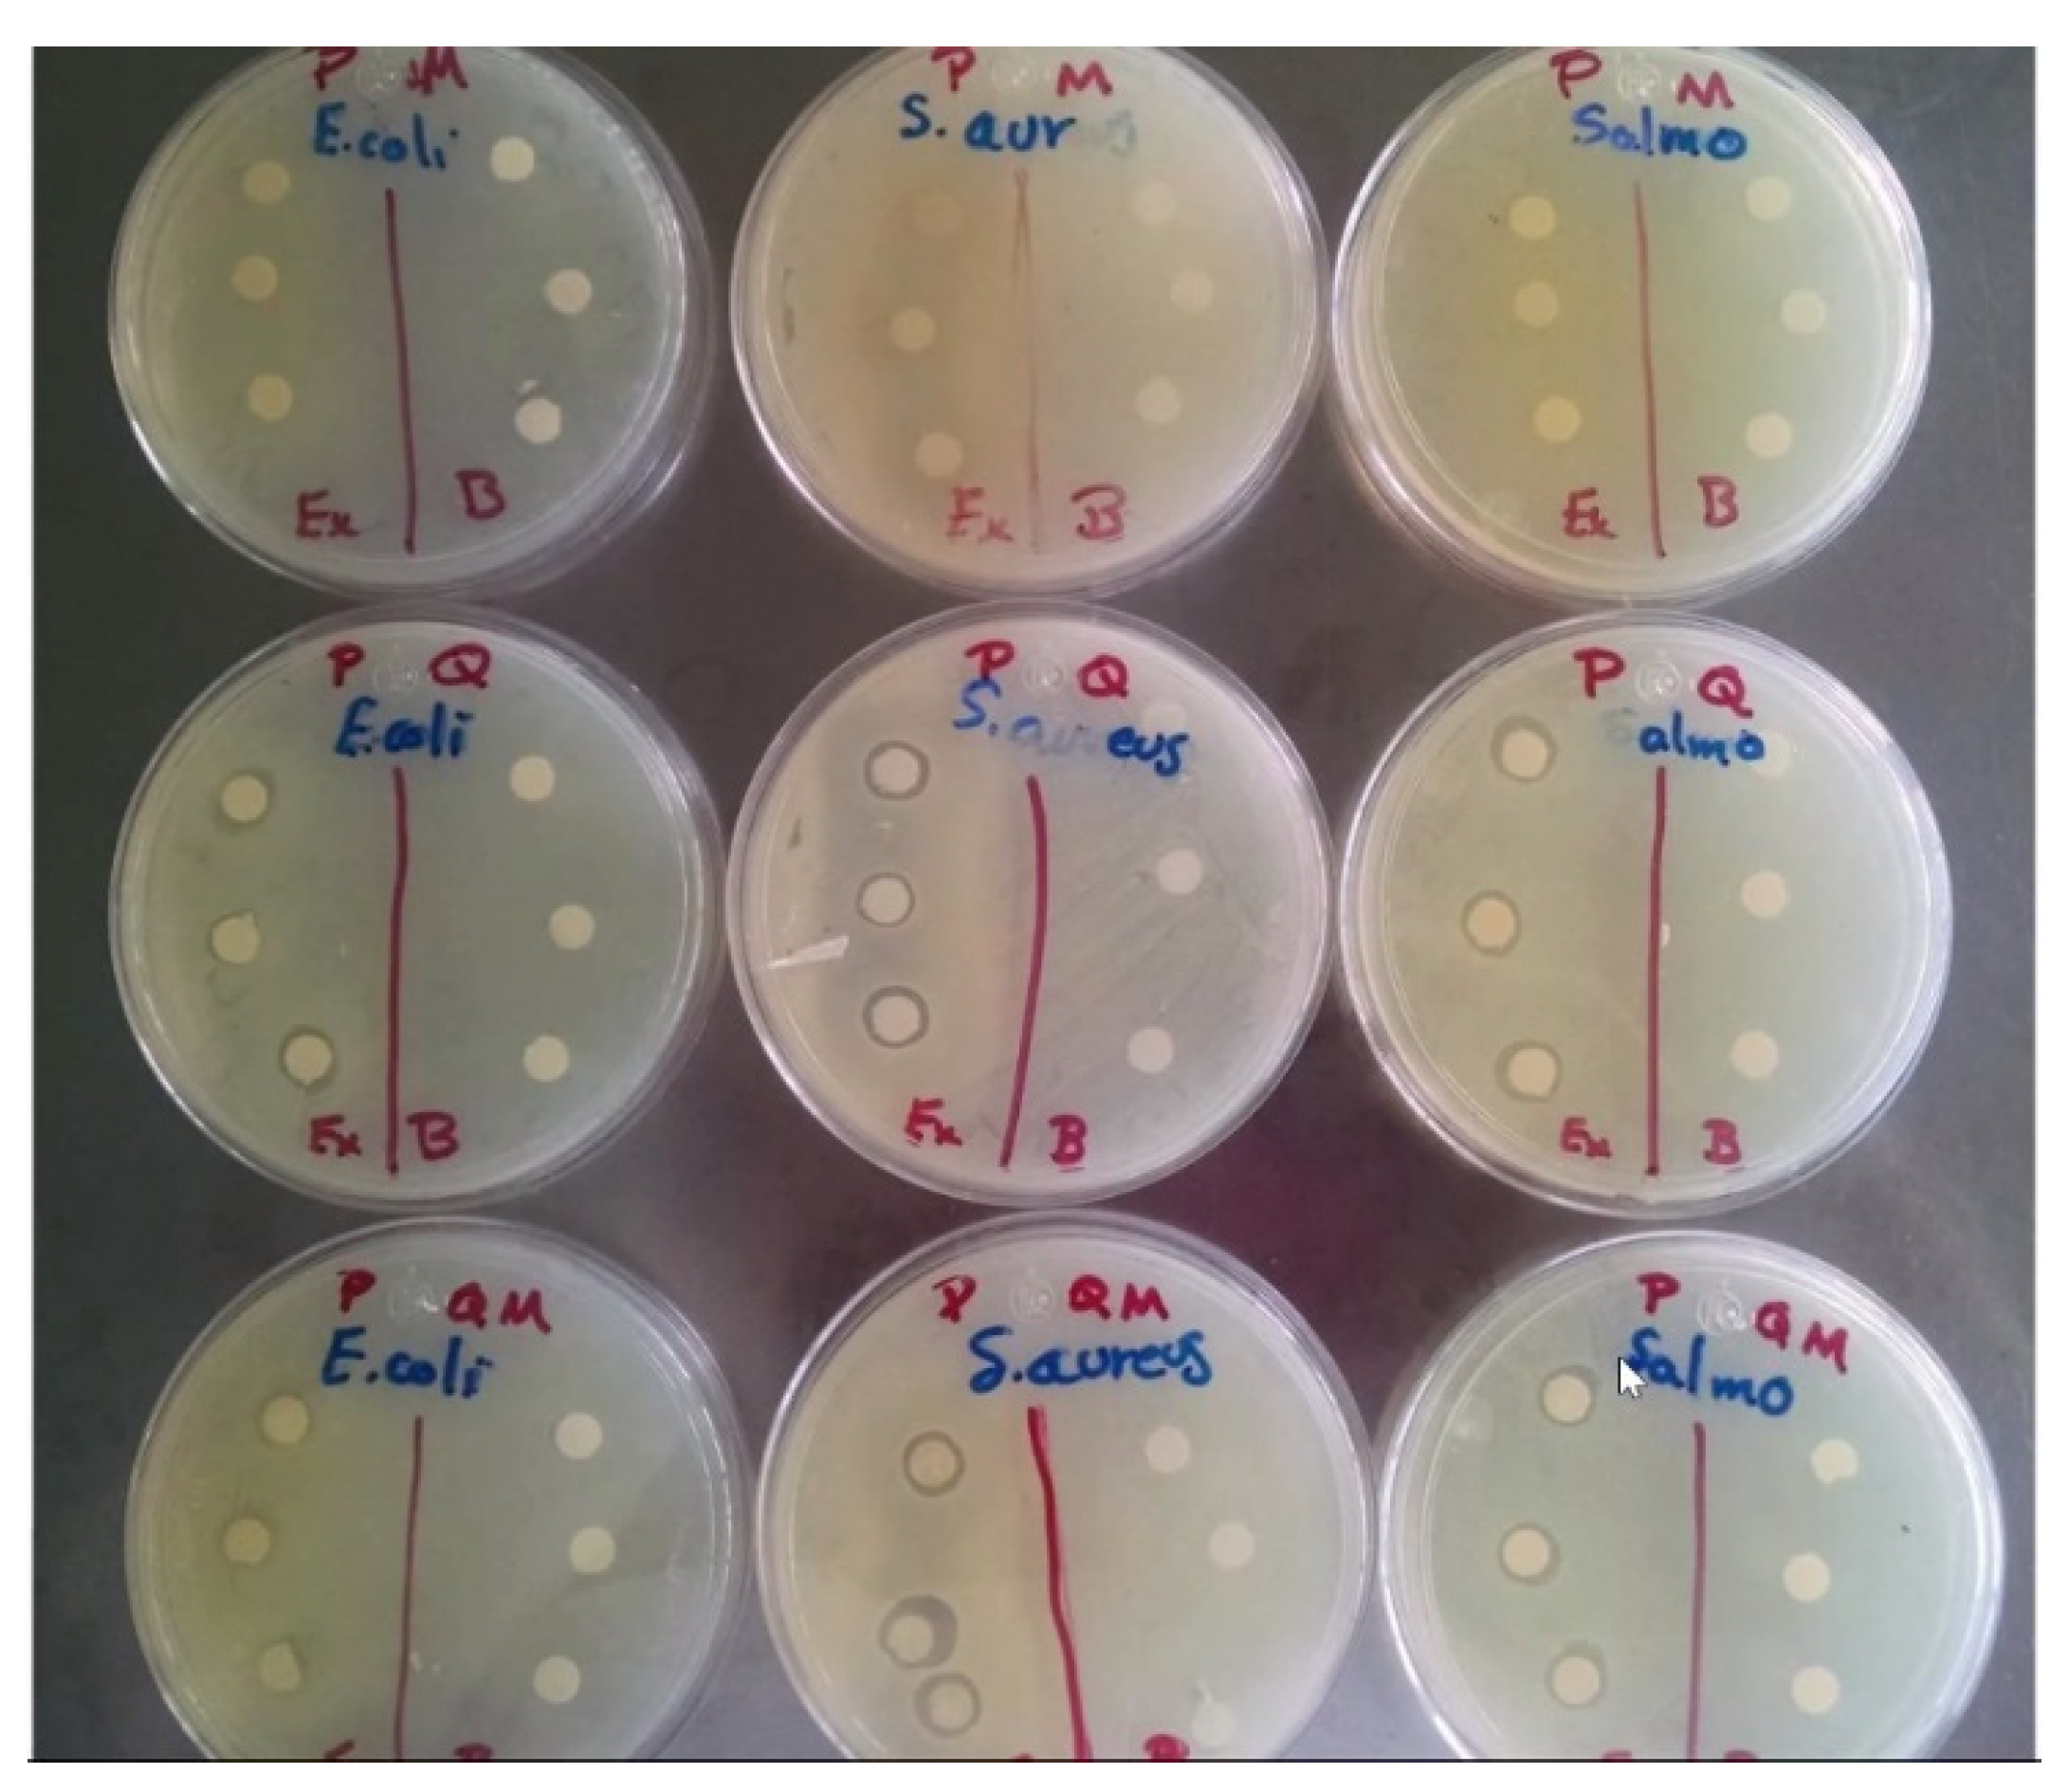
Polymers 13 03243 g002

Effects of Peppermint Extract and Chitosan-Based Edible Coating on Storage Quality of Common Carp (Cyprinus carpio) Fillets
Abstract
:1. Introduction
2. Materials and Methods
2.1. Materials
2.1.1. Fish Sample Preparation
2.1.2. Extract with Antioxidant Activity
2.1.3. Preparation for Edible Coating (EC) Solutions and Treated Fillets
2.2. Microbiological Analyses
2.2.1. Determination of Antibacterial Activity
Bacterial Strains
2.2.2. Antibacterial Activity
2.2.3. Bacteriological Analyses
2.3. Antioxidant Capacity
2.3.1. Determination of Total Phenolic Compounds
2.3.2. Free-Radical Scavenging Activity
2.4. Physicochemical Analyses
2.4.1. Myofibrillar Protein Extraction
2.4.2. Solubility
2.4.3. pH
2.4.4. Determination of Total Volatile Basic Nitrogen (TVB-N) Content
2.5. Biomolecules Oxidation
2.5.1. Determination of Lipid Peroxidation (LPX)
2.5.2. Determination of Hydroperoxide Content (HPC)
2.5.3. Determination of Protein Carbonyl Content (PCC)
2.5.4. Total Sulfhydryl (SH) Content
2.5.5. SDS-PAGE (Sodium Dodecyl Sulfate-Polyacrylamide Gel Electrophoresis)
2.6. Statistical Analysis
3. Results and Discussion
3.1. Microbiological Analyses
3.1.1. Determination of the Antibacterial Activity of Peppermint Extract and Coating Solutions
3.1.2. Bacteriological Analyses
3.2. Physicochemical Analyses
Solubility, pH and TVB-N Content
3.3. Antioxidant Capacity
3.4. Oxidation of Lipids and Proteins
3.5. SDS-PAGE
4. Conclusions
Author Contributions
Funding
Institutional Review Board Statement
Informed Consent Statement
Data Availability Statement
Acknowledgments
Conflicts of Interest
References
- Amaral, A.B.; da Silva, M.V.; da Silva Lannes, S.C. Lipid oxidation in meat: Mechanisms and protective factors—A review. Food Sci. Technol. 2018, 38, 2–15. [Google Scholar] [CrossRef] [Green Version]
- Suhag, R.; Kumar, N.; Trajkovska Petkoska, A.; Upadhyay, A. Film formation and deposition methods of edible coating on food products: A review. Food Res. Int. 2020, 136, 109582. [Google Scholar] [CrossRef]
- Petzold, G.; Gianelli, M.P.; Bugueño, G.; Celan, R.; Pavez, C.; Orellana, P. Encapsulation of liquid smoke flavoring in ca-alginate and ca-alginate-chitosan beads. J. Food Sci. Technol. 2013, 51, 183–190. [Google Scholar] [CrossRef] [Green Version]
- López-Caballero, M.E.; Gómez-Guillén, M.C.; Pérez-Mateos, M.; Montero, P. A chitosan–gelatin blend as a coating for fish patties. Food Hydrocoll. 2005, 19, 303–311. [Google Scholar] [CrossRef] [Green Version]
- Dutta, P.K.; Tripathi, S.; Mehrotra, G.K.; Dutta, J. Perspectives for chitosan-based antimicrobial films in food applications. Food Chem. 2009, 114, 1173–1182. [Google Scholar] [CrossRef]
- Ojagh, S.M.; Rezaei, M.; Razavi, S.H.M.; Hosseini, S.M.H. Effect of chitosan coatings enriched with cinnamon oil on the quality of refrigerated rainbow trout. Food Chem. 2010, 120, 193–198. [Google Scholar] [CrossRef]
- Yu, D.; Regenstein, J.M.; Xia, W. Bio-based edible coatings for the preservation of fishery products: A Review. Crit. Rev. Food Sci. Nutr. 2018, 59, 2481–2493. [Google Scholar] [CrossRef]
- Hassan, B.; Chatha, S.A.S.; Hussain, A.I.; Zia, K.M.; Akhtar, N. Recent advances on polysaccharides, lipids and protein based edible films and coatings: A review. Int. J. Biol. Macromol. 2018, 109, 1095–1107. [Google Scholar] [CrossRef] [PubMed]
- Mohamed, S.A.A.; El-Sakhawy, M.; El-Sakhawy, M.A.-M. Polysaccharides, Protein and Lipid -Based Natural Edible Films in Food Packaging: A Review. Carbohidr. Polym. 2020, 238, 116178. [Google Scholar] [CrossRef]
- Cheng, Y.; Hu, J.; Wu, S. Chitosan based coatings extend the shelf-life of beef slices during refrigerated storage. LWT 2021, 138, 110694. [Google Scholar] [CrossRef]
- Nowzari, F.; Shábanpour, B.; Ojagh, S.M. Comparison of chitosan-gelatin composite and bilayer coating and film effect on the quality of refrigerated rainbow trout. Food Chem. 2013, 141, 1667–1672. [Google Scholar] [CrossRef]
- Liu, X.; Huang, Z.; Jia, S.; Zhan, J.; Li, K.; Luo, Y. The roles of bacteria in the biochemical changes of chill-stored bighead carp (Aristichthys nobilis): Proteins degradation, biogenic amines accumulation, volatiles production, and nucleotides catabolism. Food Chem. 2018, 255, 174–181. [Google Scholar] [CrossRef]
- Moniruzzaman, M.; Kumar, S.; Das, D.; Sarbajna, A.; Chakraborty, S.B. Enzymatic, non enzymatic antioxidants and glucose metabolism enzymes response differently against metal stress in muscles of three fish species depending on different feeding niche. Ecotoxicol. Environ. Saf. 2020, 202, 110954. [Google Scholar] [CrossRef] [PubMed]
- Hussain, M.; Sumon, T.; Mazumder, S.; Ali, M.; Jang, W.J.; Abualreesh, M.; Sharifuzzaman, S.M.; Brown, C.; Lee, H.T.; Lee, E.W.; et al. Essential oils and chitosan as alternatives to chemical preservatives for fish and fisheries products: A review. Food Control 2021, 129, 108244. [Google Scholar] [CrossRef]
- Li, T.; Hub, W.; Li, J.; Zhang, X.; Zhu, J.; Li, X. Coating effects of tea polyphenol and rosemary extract combined with chitosan on the storage quality of large yellow croaker (Pseudosciaena crocea). Food Control 2012, 25, 101–106. [Google Scholar] [CrossRef]
- Li, T.; Li, J.; Hu, W.; Li, X. Quality enhancement in refrigerated red drum (Sciaenops ocellatus) fillets using chitosan coatings containing natural preservatives. Food Chem. 2013, 138, 821–826. [Google Scholar] [CrossRef] [PubMed]
- Alsaggaf, M.S.; Moussa, S.H.; Tayel, A.A. Application of fungal chitosan incorporated with pomegranate peel extract as edible coating for microbiological, chemical and sensorial quality enhancement of Nile tilapia fillets. Int. J. Biol. Macromol 2017, 99, 499–505. [Google Scholar] [CrossRef] [PubMed]
- Rajalakshmi, A.; Krithiga, N.; Jayachitra, A. Antioxidant Activity of the Chitosan Extracted from Shrimp Exoskeleton. Middle East J. Sci. Res. 2013, 16, 1446–1451. [Google Scholar]
- Kanatt, S.R.; Chander, R.; Sharma, A. Chitosan and mint mixture: A new preservative for meat and meat products. Food Chem. 2008, 107, 845–852. [Google Scholar] [CrossRef]
- Singh, R.; Shushni, M.A.M.; Belkheir, A. Antibacterial and antioxidant activities of Mentha piperita L. Arab. J. Chem. 2015, 8, 322–328. [Google Scholar] [CrossRef] [Green Version]
- Pavlić, B.; Teslić, N.; Zengin, G.; Đurović, S.; Rakić, D.; Cvetanović, A.; Gunes, A.K.; Zeković, Z. Antioxidant and enzyme-inhibitory activity of peppermint extracts and essential oils obtained by conventional and emerging extraction techniques. Food Chem. 2021, 338, 127724. [Google Scholar] [CrossRef]
- Liu, T.; Wang, J.; Chi, F.; Tan, Z.; Liu, L. Development and Characterization of Novel Active Chitosan Films Containing Fennel and Peppermint Essential Oils. Coatings 2020, 10, 936. [Google Scholar] [CrossRef]
- Kavas, G.; Kavas, N. The effects of mint (Mentha spicata) essential oil fortified edible films on the physical, chemical and microbiological characteristics of lor cheese. J. Food Agric. Environ. 2014, 12, 40–45. [Google Scholar]
- Scartazzini, L.; Tosati, J.V.; Cortez, D.H.C.; Rossi, M.J.; Flôres, S.H.; Hubinger, M.D.; Di Luccio, M.; Monteiro, A.R. Gelatin edible coatings with mint essential oil (Mentha arvensis): Film characterization and antifungal properties. J. Food Sci. Technol. 2019, 56, 4045–4056. [Google Scholar] [CrossRef] [PubMed]
- García-Argueta, I.; Quintero-Salazar, B.; Dominguez-Lopez, A.; Gómez-Oliván, L.M.; Díaz-Bandera, D.; Dublán-García, O. Effect of edible coating based on whey, inulin and gelatine with Lactobacillus casei on the textural and sensorial properties of a cracker cookie. J. Prob. Health 2016, 4, 153. [Google Scholar]
- Kanatt, S.R.; Rao, M.S.; Chawla, S.P.; Sharma, A. Active chitosan–polyvinyl alcohol films with natural extracts. Food Hydrocoll. 2012, 29, 290–297. [Google Scholar] [CrossRef]
- Ramos-García, M.L.; Bautista-Baños, S.; Barrera-Necha, L.L.; Bosquez-Molina, E.; Alia-Tejacal, I.; Estrada-Carrillo, M. Antimicrobial compounds added in edible coatings for use in horticultural products. Rev. Mex. Fitopatol. 2010, 28, 44–57. [Google Scholar]
- NOM-092-SSA1-1994. Método Para la Cuenta de Bacterias Aerobias en Placa. Mexico City: Secretaría de Salud. Diario Oficial de la Federación. 1994. Available online: http://www.salud.gob.mx/unidades/cdi/nom/092ssa14.html (accessed on 20 August 2021).
- Sallam, K.I. Antimicrobial and antioxidant effects of sodium acetate, sodium lactate, and sodium citrate in refrigerated sliced salmon. Food Control 2007, 18, 566–575. [Google Scholar] [CrossRef] [Green Version]
- Gao, L.; Oomah, B.D.; Mazza, G. Wheat Quality: Antioxidant Activity Wheat Millstreams. In Wheat Quality Elucidation; Oomah, D., Mazza, G., Eds.; AACC International Press: St. Paul, MN, USA, 2002; pp. 219–233. [Google Scholar]
- Ranilla, L.G.; Kwon, Y.I.; Apostolidis, E.; Shetty, K. Phenolic compounds antioxidant activity and in vitro inhibitory potential against key enzymes relevant for hyperglycemia and hypertension of commonly used medicinal plants, herbs and spices in Latin America. Bioresour Technol. 2010, 101, 4676–4689. [Google Scholar] [CrossRef]
- Ngapo, T.; Wilkinson, B.; Chong, R.; Haisman, D. Gelation of bovine myofibrillar protein induced by 1,5 Gluconolacone. In Proceedings of the 38th International Congress of Meat Science and Technology, Clermont-Ferrand, France, 23–28 August 1992; pp. 1095–1098. [Google Scholar]
- Gornall, A.J.; Bardawill, C.J.; David, M.M. Determination of serum proteins by means of the biuret reaction. Biol. Chem. 1949, 177, 751–766. [Google Scholar] [CrossRef]
- Pilosof, A.M.R. Solubilidad. In Caracterización Funcional y Estructural de Proteínas; Pilosof, A.M.R., Barholomai, G.B., Eds.; Ceudeba CYTED (Programa Iberoamericano de Ciencia y Tecnología Para el Desarrollo): Buenos Aires, Argentina, 2000; pp. 60–75. [Google Scholar]
- Owen, J.E.; Nuñez, F.A.; Arias, M.T.; De Cano, R.; Rios, O. Manual de Prácticas de Cursos de Tecnologías de la Carne; Facultad de Zootecnia, Universidad de Chihuahua: Chihuahua, Mexico, 1982; p. 132. [Google Scholar]
- Conway, E.J.; Byrne, A. An absorption apparatus for the micro-determination of certain volatile substances I. The micro-determination of ammonia. J. Biochem. 1936, 27, 419–429. [Google Scholar]
- Büege, J.A.; Aust, S.D. Microsomal lipid peroxidation. Methods Enzymol. 1978, 52, 302–310. [Google Scholar]
- Jiang, Z.Y.; Hunt, J.V.; Wolff, S.P. Ferrous ion oxidation in the presence of xylenol orange for detection of lipid hydroperoxide in low density lipoprotein. Anal. Biochem. 1992, 202, 384–389. [Google Scholar] [CrossRef]
- Levine, R.L.; Williams, J.A.; Stadtman, E.R.; Shacter, E. Carbonyl assays for determination of oxidatively modified proteins. Methods Enzymol. 1994, 233, 346–357. [Google Scholar] [PubMed]
- Parvez, S.; Raisuddin, S. Protein carbonyls: Novel biomarkers of exposure to oxidative stress-inducing pesticides in freshwater fish Channa punctata (Bloch). Environ. Toxicol. Pharmacol. 2005, 20, 112–117. [Google Scholar] [CrossRef] [PubMed]
- Burcham, P.C. Modified protein carbonyl assay detects oxidized membrane proteins: A new tool for assessing drug- and chemically-induced oxidative cell injury. J. Pharmacol. Toxicol. Methods 2007, 56, 18–22. [Google Scholar] [CrossRef]
- Ellman, G.L. Tissue sulfhydryl groups. Arch. Biochem. Biophys. 1959, 82, 70–77. [Google Scholar] [CrossRef]
- Laemmli, U.K. Cleavage of structural proteins during the assembly of the head of bacteriophage T4. Nature 1970, 227, 680–685. [Google Scholar] [CrossRef]
- Al-Hadi, L.M. The antibacterial activity of aqueous extract of peppermint and Bay leaf against Staphylococcus aureus. J. Bagh. Coll. Dent. 2011, 23, 146–150. [Google Scholar]
- Zheng, L.Y.; Zhu, J.F. Study on antimicrobial activity of chitosan with different molecular weights. Carbohydr. Polym. 2003, 54, 527–530. [Google Scholar] [CrossRef]
- Ouattara, B.; Simard, R.E.; Holley, R.A.; Piette, G.J.P.; Bégin, A. Antibacterial activity of selected fatty acids and essential oils against six meat spoilage organisms. Int. J. Food Microb. 1997, 37, 155–162. [Google Scholar] [CrossRef]
- Ramezani, Z.; Zarei, M.; Raminnejad, N. Comparing the effectiveness of chitosan and nanochitosan coatings on the quality of refrigerated silver carp fillets. Food Control 2015, 51, 43–48. [Google Scholar] [CrossRef]
- ICMSF (International Commission on Microbiological Specifications for Foods). Microorganisms in foods. In Sampling for Microbiological Analysis: Principles and Specific Applications, 2nd ed.; University of Toronto Press: Toronto, ON, Canada, 1986. [Google Scholar]
- YB, B.; Kola, M. Influence of composite edible coating systems on preservation of fresh meat cuts and products: A brief review on their trends and applications. Int. Food Res. J. 2019, 26, 377–392. [Google Scholar]
- Motalebi, A.; Seyfzadeh, M. Effects of whey protein edible coating on bacterial, chemical and sensory characteristics of frozen common Kilka (Clupeonellia delitula). Iran J. Fish Sci. 2011, 11, 132–144. [Google Scholar]
- Ju, J.; Xie, Y.; Guo, Y.; Cheng, Y.; Qian, H.; Yao, W. Application of edible coating with essential oil in food preservation. Crit Rev. Food Sci. Nutr. 2019, 59, 2467–2480. [Google Scholar] [CrossRef] [PubMed]
- Benítez, R.; Ibarz, A.; Pagan, J. Protein hydrolysates: Processes and applications. Acta Bioquim. Clin. Latinoam. 2008, 42, 227–236. [Google Scholar]
- Mehta, N.K.; Elavarasan, K.; Reddy, A.M.; Shamasundar, B.A. Effect of ice storage on the functional properties of proteins from a few species of fresh water fish (Indian major carps) with special emphasis on gel forming ability. J. Food Sci. Technol. 2014, 51, 655–663. [Google Scholar] [CrossRef] [Green Version]
- Sun, X.; Guo, X.; Ji, M.; Wu, J.; Zhu, W.; Wang, J.; Cheng, C.; Chen, L.; Zhang, Q. Preservative effects of fish gelatin coating enriched with CUR/βCD emulsion on grass carp (Ctenopharyngodon idellus) fillets during storage at 4 °C. Food Chem. 2019, 30, 643–652. [Google Scholar] [CrossRef]
- Yu, D.; Jiang, Q.; Xu, Y.; Xia, W. The shelf life extension of refrigerated grass carp (Ctenopharyngodon idellus) fillets by chitosan coating combined with glycerol monolaurate. Int. J. Biol. Macromol. 2017, 101, 448–454. [Google Scholar] [CrossRef] [PubMed]
- Ocaño-Higuera, V.M.; Maeda-Martínez, A.N.; Márquez-Ríos, E.; Canizales-Rodríguez, D.; Castillo-Yáñez, F.J.; Ruíz-Bustos, E.; Graciano-Verdugo, A.Z.; Plascencia-Jatomea, M. Freshness assessment of ray fish stored in ice by biochemical, chemical and physical methods. Food Chem. 2011, 125, 49–54. [Google Scholar] [CrossRef]
- Wang, Z.; Hu, S.; Gao, Y.; Ye, C.; Wang, H. Effect of collagen-lysozyme coating on fresh-salmon fillets preservation. LWT 2017, 75, 59–64. [Google Scholar] [CrossRef]
- Giménez, B.; Roncalés, P.; Beltrán, J.A. Modified atmosphere packaging of filleted rainbow trout. J. Sci. Food Agric. 2002, 82, 1154–1159. [Google Scholar] [CrossRef]
- Karoui, R.; Hassoun, A. Efficiency of rosemary and basil essential oils on the shelf-life extension of Atlantic mackerel (Scomber scombrus) fillets stored at 2 °C. J. AOAC Int. 2017, 100, 335–344. [Google Scholar] [CrossRef] [Green Version]
- Yu, D.; Wu, L.; Regenstein, J.M.; Jiang, Q.; Yang, F.; Xu, Y.; Xia, W. Recent advances in quality retention of non-frozen fish and fishery products: A review. Crit. Rev. Food Sci. Nutr. 2019, 60, 1–13. [Google Scholar] [CrossRef]
- Elansary, H.O.; Szopa, A.; Kubica, P.; Ekiert, H.; Klimek-Szczykutowicz, M.; El-Ansary, D.O.; Mahmoud, E.A. Polyphenol Profile and Antimicrobial and Cytotoxic Activities of Natural Mentha piperita and Mentha longifolia Populations in Northern Saudi Arabia. Processes 2020, 8, 479. [Google Scholar] [CrossRef] [Green Version]
- Farnad, N.; Heidari, R.; Aslanipour, B. Phenolic composition and comparison of antioxidant activity of alcoholic extracts of Peppermint (Mentha piperita). J. Food Meas. Charact. 2014, 8, 113–121. [Google Scholar] [CrossRef]
- Tahira, R.; Naeemullah, M.; Akbar, F.; Masood, M.S. Major phenolic acids of local and exotic mint germplasm grown in Islamabad. Pak. J. Bot. 2011, 43, 151–154. [Google Scholar]
- Brown, N.; John, J.A.; Shahidi, F. Polyphenol composition and antioxidant potential of mint leaves. Food Prod. Process Nutr. 2019, 1, 1–14. [Google Scholar] [CrossRef] [Green Version]
- Jeon, Y.I.; Kamil, J.Y.V.A.; Shahidi, F. Chitosan as an edible invisible film for quality preservation of herring and Atlantic cod. J. Agric. Food Chem. 2002, 20, 5167–5178. [Google Scholar] [CrossRef] [PubMed]
- Sample, S. Oxidation and Antioxidants in Fish and Meat from Farm to Fork. In Food Industry; Muzzalupo, I., Ed.; InTech Publishing: Rijeka, Croatia, 2013; pp. 114–144. [Google Scholar] [CrossRef] [Green Version]
- Estévez, M. Protein carbonyls in meat systems: A review. Meat Sci. 2011, 89, 259–279. [Google Scholar] [CrossRef]
- Eymard, S.; Baron, C.P.; Jacobsen, C. Oxidation of lipid and protein in horse mackerel (Trachurus trachurus) mince and washed minces during processing and storage. Food Chem. 2009, 114, 57–65. [Google Scholar] [CrossRef]
- Listrat, A.; Lebret, B.; Louveau, I.; Astruc, T.; Bonnet, M.; Lefaucheur, L.; Bugeon, J. How muscle structure and composition influence meat and flesh quality. Sci. World J. 2016, 3182746, 1–14. [Google Scholar] [CrossRef] [Green Version]
- Sun, L.; Sun, J.; Thavaraj, P.; Yang, X.; Guo, Y. Effects of thinned young apple polyphenols on the quality of grass carp (Ctenopharyngodon idellus) surimi during cold storage. Food Chem. 2017, 224, 372–381. [Google Scholar] [CrossRef]
- Kjærsgård, I.V.H.; Nørrelykke, M.R.; Baron, C.P.; Jessen, F. Identification of carbonylated protein in frozen rainbow trout (Oncorhynchus mykiss) fillets and development of protein oxidation during frozen storage. J. Agric. Food Chem. 2006, 54, 9437–9446. [Google Scholar] [CrossRef] [PubMed]
- Shi, C.; Cui, J.; Yin, X.; Luo, Y.; Zhou, Z. Grape seed and clove bud extracts as natural antioxidants in silver carp (Hypophthalmichthys molitrix) fillets during chilled storage: Effect on lipid and protein oxidation. Food Control 2014, 40, 134–139. [Google Scholar] [CrossRef]
- Amorati, R.; Foti, M.; Valgimigli, L. Antioxidant Activity of Essential Oils. J. Agric. Food Chem. 2013, 61, 10835–10847. [Google Scholar] [CrossRef]
- Passi, S.; Cataudella, S.; Tiano, L.; Littarru, G.P. Dynamics of lipid oxidation and antioxidant depletion in Mediterranean fish stored at different temperatures. BioFactors 2005, 25, 241–254. [Google Scholar] [CrossRef]
- Farvin, K.H.S.; Grejsen, H.D.; Jacobsen, C. Potato peel extract as a natural antioxidant in chilled storage of minced horse mackerel (Trachurus trachurus): Effect on lipid and protein oxidation. Food Chem. 2012, 131, 843–851. [Google Scholar] [CrossRef]
- Nie, X.; Lin, L.; Zhang, Q. Proteolytic characterisation in grass carp sausage inoculated with Lactobacillus plantarum and Pediococcus pentosaceus. Food Chem. 2014, 145, 840–844. [Google Scholar] [CrossRef]

Publisher’s Note: MDPI stays neutral with regard to jurisdictional claims in published maps and institutional affiliations. |
© 2021 by the authors. Licensee MDPI, Basel, Switzerland. This article is an open access article distributed under the terms and conditions of the Creative Commons Attribution (CC BY) license (https://creativecommons.org/licenses/by/4.0/).
Share and Cite
Morachis-Valdez, A.G.; Santillán-Álvarez, Á.; Gómez-Oliván, L.M.; García-Argueta, I.; Islas-Flores, H.; Dublán-García, O. Effects of Peppermint Extract and Chitosan-Based Edible Coating on Storage Quality of Common Carp (Cyprinus carpio) Fillets. Polymers 2021, 13, 3243. https://doi.org/10.3390/polym13193243
Morachis-Valdez AG, Santillán-Álvarez Á, Gómez-Oliván LM, García-Argueta I, Islas-Flores H, Dublán-García O. Effects of Peppermint Extract and Chitosan-Based Edible Coating on Storage Quality of Common Carp (Cyprinus carpio) Fillets. Polymers. 2021; 13(19):3243. https://doi.org/10.3390/polym13193243
Chicago/Turabian StyleMorachis-Valdez, Ana Gabriela, Ángel Santillán-Álvarez, Leobardo Manuel Gómez-Oliván, Imelda García-Argueta, Hariz Islas-Flores, and Octavio Dublán-García. 2021. "Effects of Peppermint Extract and Chitosan-Based Edible Coating on Storage Quality of Common Carp (Cyprinus carpio) Fillets" Polymers 13, no. 19: 3243. https://doi.org/10.3390/polym13193243
APA StyleMorachis-Valdez, A. G., Santillán-Álvarez, Á., Gómez-Oliván, L. M., García-Argueta, I., Islas-Flores, H., & Dublán-García, O. (2021). Effects of Peppermint Extract and Chitosan-Based Edible Coating on Storage Quality of Common Carp (Cyprinus carpio) Fillets. Polymers, 13(19), 3243. https://doi.org/10.3390/polym13193243

